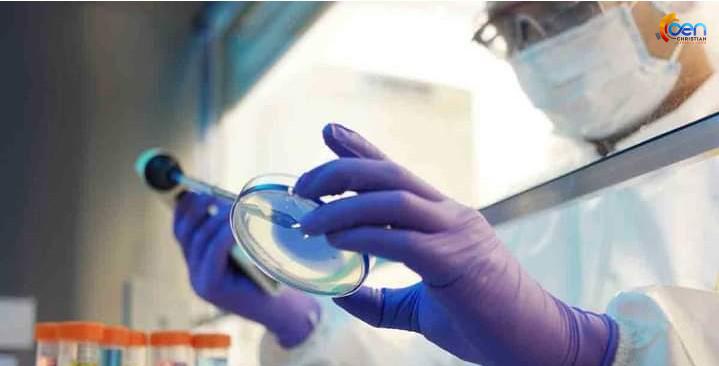

TOP NEWS| ആശ്വാസമായി പരിശോധനാ ഫലം; നിപ്പ ലക്ഷണങ്ങളുമായി ചികിത്സയിലായിരുന്ന എട്ടുപേരുടെ പരിശോധനാ ഫലം നെഗറ്റീവ്
ആശ്വാസമായി പരിശോധനാ ഫലം; നിപ്പ ലക്ഷണങ്ങളുമായി ചികിത്സയിലായിരുന്ന എട്ടുപേരുടെ പരിശോധനാ ഫലം നെഗറ്റീവ്
കോഴിക്കോട്: നിപ്പ ലക്ഷണങ്ങളുമായി ചികിത്സയിലായിരുന്നു എട്ടുപേരുടെ സ്രവസാംപിൾ പരിശോധനാ ഫലം നെഗറ്റീവ്. നിപ്പ ബാധിച്ചു മരിച്ച 12 വയസ്സുകാരനുമായി അടുത്തിടപഴകിയ ബന്ധുക്കളുടെയും ആരോഗ്യപ്രവർത്തകരുടെയും സാംപിളുകളാണിവ. പുണെ വൈറോളജി ഇൻസിറ്റിറ്റ്യൂട്ടിലെ പരിശോധനയിലാണ് നെഗറ്റീവാണെന്ന് സ്ഥിരീകരിച്ചത്. ആശ്വാസകരമായ വാർത്തയാണെന്നും എല്ലാവരുടെയും ആരോഗ്യനില തൃപ്തികരമെന്നും ആരോഗ്യമന്ത്രി വീണാ ജോർജ് പറഞ്ഞു.


